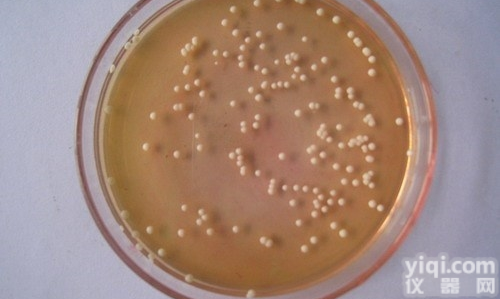
MS盐与B5<em>维生素</em><em>混合</em>物培养基价格

BCR-485 混合蔬菜中(维生素)标准物质 25g
- 品牌:BCR/ERM/IRMM欧盟标准品 标准物质
- 型号:BCR/ERM/IRMM欧盟标准品 标准物质
- 产地:进口
- 供应商:北京博研科创生物技术有限公司
- 供应商报价:咨询电话13552204976,www.gbw600.cn
- 标签:BCR-485 混合蔬菜中(维生素)标准物质 25g, 货号:BCR-485,CAS号:,BCR/ERM/IRMM欧盟标准品 标准物质, BCR/ERM/IRMM欧盟标准品 标准物质, 北京博研科创生物技术有限公司,BCR-485 混合蔬菜中(维生素)标准物质 25g报价/价格,销售,使用,原理,操作,说明书,资料下载,促销,技术参数,维修,保修,售后服务,代理商,经销商,技术支持,进口/国产,用途